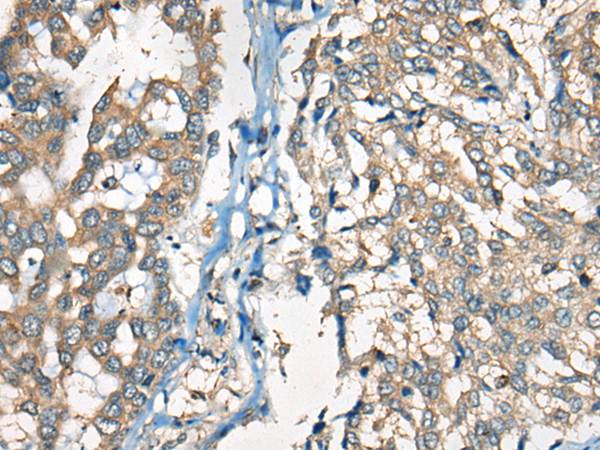

|
Background: |
Immunoglobulins belong to a group of related glyco proteins which make up 20% of serum proteins. Antigens and immunoglobulins react to confer immunity to individuals. Immunoglobulins have similar structures of two identical heavy chains and two identical light chains. Both the heavy chains and the light chains are divided into constant and variable regions. The constant regions have the same amino acid sequences between all the immunoglobulin classes. The variable regions have approximately 110 amino acids with high sequence variability. The amino acid sequence of the heavy chain determines the class of an immunoglobulin. The five types of immunoglobulin heavy chains are known as: IgG, IgA, IgM, IgD, and IgE. IgG is divided into four subclasses, and IgA is divided into two subclasses. In serum IgA and IgG are monomers with a single 4 polypeptide unit; while, IgM is a pen tamer. IgA may also form polymers. Kappa light chain antibody can be used for the identification of leukemias, plasmacytomas and certain non Hodgkin's lymphomas. Kappa light chain contains one immunoglobulin like domain. The EU sequence has the INV allotypic marker, Ala 45 and Val 83. The ROY sequence has the INV allotypic marker, Ala 45 and Leu 83. |
|
Applications: |
ELISA, IHC |
|
Name of antibody: |
Kappa Light chain |
|
Immunogen: |
Synthetic peptide of human Kappa Light chain |
|
Full name: |
Kappa Light chain |
|
SwissProt: |
P01608 |
|
ELISA Recommended dilution: |
5000-10000 |
|
IHC positive control: |
Human liver cancer |
|
IHC Recommend dilution: |
20-100 |
購(gòu)物車(chē)
幫助
021-54845833/15800441009
